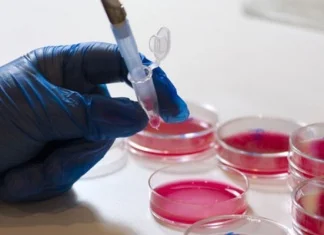
Naučnici ćelije raka pretvorili u salo

Tag: ćelije raka
Naučnici ćelije raka pretvorili u salo
Stručnjaci sa Univerziteta u Bazelu uspjeli su da natjeraju ćelije raka dojke da se pretvore u salo i time postanu potpuno bezopasne.
Da bi postigli...
Prvi lijekovi protiv raka mogli bi biti dostupni i na tržištu
Prvi lijekovi na svijetu koji su namijenjeni da potpuno zaustave otpornost ćelija raka na liječenje mogli bi biti dostupni u narednih deset godina, kažu...
Kako hronični stres potiče rast stanica raka?
Nakon novog istraživanja znanstvenici kažu da bolje shvaćaju kako hronični stres utiče na ubrzanje rasta ćelija raka. Također, otkrili su i na koji način...
Znanstvenici ćelije raka uspjeli pretvoriti u bezopasne masne stanice
Pretvaranje opasnih stanica raka u posve bezopasne masne naslage zvuči kao znanstvena fantastika.
Međutim, švicarski su znanstvenici postigli upravo to, u novom istraživanju provedenom...